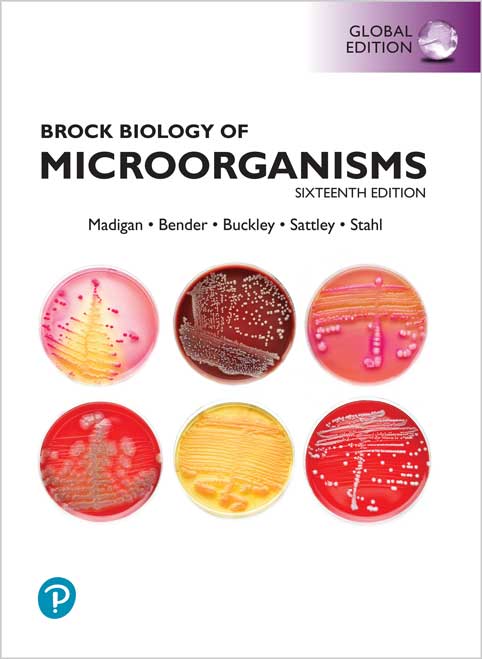

Harness AI to Solve Real-World Biology Problems
Charles Ravarani and Natasha Latysheva

#Deep_Learning
#Biology
#DNA
#GNN
#CNN
#Transformers
#Autoencoders
📘 فاصله میان یادگیری ماشین مدرن و زیستشناسی واقعی را با این راهنمای عملی و پروژهمحور از میان بردارید.
چه پیشزمینهی شما در زیستشناسی، مهندسی نرمافزار یا علم داده باشد، کتاب Deep Learning for Biology ابزارهایی را در اختیار شما قرار میدهد تا مدلهای یادگیری عمیق را برای حل طیف گستردهای از مسائل زیستی توسعه دهید.
🧬 نویسندگان، «چارلز راوارانی» و «ناتاشا لاتیشوا»، شما را گامبهگام در پروژههای عملی راهنمایی میکنند تا یادگیری عمیق را در حوزههایی همچون DNA، پروتئینها، شبکههای زیستی، تصاویر پزشکی و میکروسکوپی به کار ببرید.
هر فصل این کتاب یک پروژهی مستقل است که با توضیحات مرحلهبهمرحله، به شما میآموزد چگونه با استفاده از دادههای واقعی زیستی، مدلهای یادگیری عمیق را آموزش، ارزیابی و تفسیر کنید.
💡 در این کتاب یاد میگیرید چگونه:
🚀 چه در حال کشف روشهای نوین باشید، چه بخواهید وارد دنیای زیستشناسی محاسباتی شوید یا یادگیری ماشین را در رشتهی خود بهکار ببندید، این کتاب مسیری روشن، کاربردی و قابلفهم پیش روی شما قرار میدهد.
👨🔬 درباره نویسندگان
👨💻 چارلز راوارانی زیستشناس و مهندس نرمافزار است و در حال حاضر بهعنوان مدیر ارشد فناوری (CTO) در شرکت biotx.ai (فعال در کشف دارو با روشهای محاسباتی) فعالیت میکند. او دکترای خود را در زیستشناسی محاسباتی از دانشگاه کمبریج دریافت کرده و سابقهای برجسته در زمینهی علمی و توسعه نرمافزار دارد. او همچنین با سازمانهای مختلف همکاری مشاورهای داشته و علاقهمند به آموزش برنامهنویسی و مباحث یادگیری ماشین است.
👩🔬 ناتاشا لاتیشوا زیستشناس و پژوهشگر یادگیری ماشین است و در حال حاضر بهعنوان پژوهشگر ارشد در Google DeepMind فعالیت میکند و در زمینهی یادگیری عمیق برای ژنومیک تخصص دارد. او دارای دکترای زیستشناسی محاسباتی از دانشگاه کمبریج است و تجربهی گستردهای در حوزههای مختلف یادگیری ماشین دارد. تمرکز او بر ایجاد پیوند میان زیستشناسی و یادگیری ماشین است و به آموزش و سادهسازی مفاهیم پیچیده علمی برای عموم علاقهمند میباشد.
Bridge the gap between modern machine learning and real-world biology with this practical, project-driven guide. Whether your background is in biology, software engineering, or data science, Deep Learning for Biology gives you the tools to develop deep learning models for tackling a wide range of biological problems.
Authors Charles Ravarani and Natasha Latysheva guide you through hands-on projects applying deep learning to domains like DNA, proteins, biological networks, medical images, and microscopy. Each chapter is a self-contained mini-project, with step-by-step explanations that teach you how to train and interpret deep learning models using real biological data.
Whether you’re exploring new methods, transitioning into computational biology, or looking to make sense of machine learning in your field, this book offers a clear and approachable path forward.
Table of Contents
Chapter 1. Introduction
Chapter 2. Learning the Language of Proteins
Chapter 3. Learning the Logic of DNA
Chapter 4. Understanding Drug–Drug Interactions Using Graphs
Chapter 5. Detecting Skin Cancer in Medical Images
Chapter 6. Learning Spatial Organization Patterns Within Cells
Chapter 7. Tips and Tricks for Deep Learning in Biology
About the Author
Charles Ravarani is a biologist and software engineer who is currently Chief Technology Officer at biotx.ai, a computational drug discovery startup. He completed his PhD and post-doc in computational biology at the University of Cambridge, and in addition to his outstanding academic contributions, Charles is a software development veteran, has consulted various organizations, and has a passion for teaching programming and machine learning topics.
Natasha Latysheva is a biologist and machine learning practitioner who is currently a Senior Research Engineer at Google DeepMind, specializing in deep learning for genomics. With a PhD in computational biology from the University of Cambridge and experience across several machine learning domains, her expertise is in bridging the gap between biology and machine learning. She is passionate about machine learning education and making complex technical topics accessible and exciting.